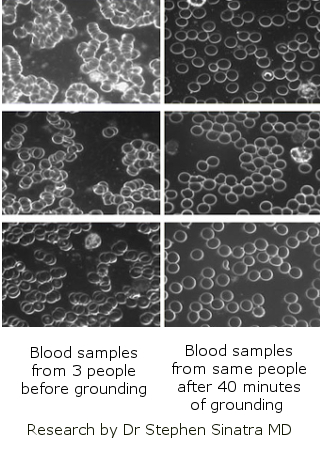
earth healing research

and move towards health
Earth Energy Healing
The knowledge of earth energy healing extends back throughout time.
It is spoken of, without words, in the sacred geometry of stone circles and cathedrals.
Many of us have experienced the revitalising power of spending time in nature.
"It was good for the skin to touch the bare earth,
and the old people liked to remove their moccasins
and walk with their bare feet on the Sacred Earth.
They sat on the ground with the feeling of being close to a mothering power…
The soil was soothing,
strengthening,
cleansing
and healing"
Luther Standing Bear
Sioux tribal leader
1868-1939
Below right: Myself, Katherine T Owen. I always rest my wrists on an earthing mat beneath my computer keyboard.
This article introduces you to products which draw on the principles of earth energy healing.
Plastics were introduced in 1957.
By 1960 plastics were
being used on the base of our shoes, effectively placing a level of insulation
between us and the Earth.
Inside the house many of us walk on synthetic
carpets.
Individual testimonies and scientific research suggest that there are health benefits when we spend time connected to the earth, for example through walking bare foot.
The theory behind earth energy healing products is that it is healing for us to maintain a physical connection with the earth whenever possible.
To be clear, you don't need to buy earthing products to earth yourself.
In order to benefit from earth energy healing, you can set
aside time to go outside and place your feet on the earth.
You can even bring a
box of earth inside the house and place your feet on it.
In practice, many of us do not do these things.
And those of us living with Chronic Fatigue Syndrome or other chronic illnesses don't have the extra movement and energy necessary to clean off our feet and hoover up the earth trodden around the house!
Luckily there are products we can buy to allow us to be earthed more easily for more of the time.
I was amazed I hadn’t heard of these products before last year. It is my pleasure to tell you about them in the hope that they will work for you as they have for me.
The benefits of earth energy healing products

How to sleep better - a product to assist you
If levels of the cortisol hormone are too high you can’t
sleep. Cortisol levels should be low at night and high in the morning.
Research shows that earthing products reinforce the correct rhythm of cortisol.
For many people an earthing sheet in the bed is the answer to how to sleep better and how to wake up feeling more refreshed
Some people report that they no longer snore when sleeping on a grounding sheet.
The image on the right shows the adaptor to my UK socket plug connected to my grounding sheet.
One end of the adaptor connects to the sheet (or the mat) and the other end plugs into the mains socket.
The products do not run on electricity but plug ONLY into the EARTHING plug in the socket which is not live.
A product to heal pain
Many people report a reduction in pain when sleeping on a grounding sheet.

A product to maintain health
Some people choose to use a grounding mat or grounding sheet even if they are already healthy or don't see clear benefits. For them the use of these products is in the category of "preventative measures". They are aware of the electrical soup in which we live and wish to keep themeselves connected with nature.
A product to help with electrical sensitivity
These earth energy healing products are not specifically recommended for those with electrical sensitivity but this was the reason they appealed to me.
When I was bedbound, I used to be so sensitive to electricity that I had to ration the amount I listened to the radio next to my bed. Now I am walking around :-), I continue to have electrical sensitivity.
For example, I do
not use a mobile phone other than for texting.
I find the symptoms of electrical sensitivity distressing. They are concerning in a world which is more and more electricity dependent– both wired and wireless.
When symptoms are high it feels as though electricity is running through me! It makes sense to me to find a way to earth myself and ensure that any electricity runs to ground.
Note of caution:
I feel more sure of recommending these earth energy healing products to help heal pain
and to help you sleep better.
Seb who runs Groundology has seen them work
well to heal pain and help sleep.
The same healing benefits, along with increased mobility, were also observed by those featured in the movie,
Grounding.
For those of you with electrical sensitivity I suspect that the earthing products will work for
some of you and not for others.
The products are plugged into a wall
socket which feels
counter intuitive!
But please remember you are connecting with ‘Earth’ not with the
electricity
circuit!
If, like myself, you have felt quite desperate at times about
the restrictions and symptoms of Electrical Sensitivity, then it is well worth trying one of these products to access earth energy healing.
The grounding mat is cheaper than the sheets. And I believe it can be returned if it is in new condition- Please check this with Seb at Groundology before you purchase.
It is worth
a go to buy something which may change your life.
Click through to Groundology on the banner below to find out more about these earth energy healing products.
Click to watch a trailer for the Grounded documentary.
Testing out the earth healing energy products
I am really glad that I ordered from the Groundology company .
Seb, who runs Groundology, was really helpful. If I had ordered through a big impersonal selling site I wouldn't have been able to ask for advice.
Groundology is based in the UK and Seb's website delivers all round the
world.
He will make sure that you know which adaptor to buy so that the
earth energy healing products can be used with the electrical sockets in your country. (No adaptor is needed in USA.)
I ordered the mat and the sheet in one go. When I spoke to Seb I found out that the sheet could not be returned once used. It has silver thread throughout, has to be washed very carefully, and cannot be resold.
So instead of starting with the sheet , I started by placing the earthing mat at the base of my bed, and putting my feet on it whilst I slept.
The mat felt cool under my feet and I would wake up to check my feet were still on it. I was amazed that even with this disturbance, I still slept far better than before.
It was only once I was convinced the grounding mat was helping that I opened and use the sheet.
You need to wash the sheet with care. It may be something that you consider repurchasing after a few years, depending on how often you wash it and how carefully.
Many of us who know what it is to lie awake in the small hours, will consider the cost of the grounding sheet a small price to pay for a natural answer to how to sleep better.
I now have the grounding mat permanently under my computer keyboard and I rest my wrists and hands on the mat whilst sitting at the computer. It just makes sense to me to be grounded whilst I am sitting surrounded by electrical equipment.
For more of my personal experience of the benefits of the earthing products, you can read extracts from my diary below.
Scientific research behind grounding
The benefits of earth energy healing are backed up by science.
Blood samples were studied during research into grounding by Dr Stephen Sinatra MD.
In the image on the right you can see darkfield microscope images of blood taken from three individuals before and after grounding for forty minutes.
The pictures show the improvement.
Some of the experiments with earthing products are with plants, which removes the possibility of placebo effect.
There are striking images of the differences between two identical flowers placed side by side, one on the grounding mat, the other not. The one on the grounding mat lasts longer. (It occurs to me that anyone who purchases a grounding mat can easily try this experiment for themselves.)
The Science of Grounding
As at 2013, there were 15 peer-reviewed studies which showed the benefits of Earth energy healing products.
(The field of science concerned with this area is called electrostatics.)
I was amazed to listen to a talk by Dr James Oschman and find out just how much scientific confirmation there is of energy medicine. I had previously considered energy medicine to be firmly in the category of alternative healing methods.
He also pointed out that ECGs and ECTs are methods used by conventional medicine and these work with the energy of the body.
James Oschman has written two books.
- Energy Medicine: the Scientific Basis
- Energy Medicine and Therapeutics in Human Performance.
My personal experience of earth energy healing products
Extracts from my diary
9 March 2013- a belated diary
I tried the earthing mat first on 27th February.
I didn't use the mat the next night because on the first day my electrical sensitivity was raised a little bit. I don't think I felt worse though in other ways. I'm pretty sure I slept better than usual.
I am trying having the mat in my bed and just making sure my foot is on it at least some of the time whilst I sleep.
When I rang Seb [at Groundology] and said I wondered if the
electrical sensitivity was worse, he said that sometimes people with electrical
sensitivity have a bad reaction and to give it six weeks.
He advised building
up. However, I haven't really done that.
Since I came back I have used the mat every
night in bed, and used it whilst on the computer during the day.
The last two nights in particular it has been noticeable that I am now getting to sleep without using a CD. It had reached the point where I would hear the end of the CD and still be awake.
12 March 2013
Lately I have been really exhausted by bed time–
unpleasantly so: a very profound tiredness that saw me go to bed before 10
o'clock. For the last 2 days of having my feet on the mat in bed I have not had
that tiredness at the end of the day.
I'm now going to bed at 10, feeling far
better than I would have expected to. I've even done some wiggling dancing!
I have now used the mat for about 2 weeks.
My hands have been noticeably better the last two days for typing.
This is a surprising result. Is the electrical sensitivity a cause of pain in the joints of the fingers?
I also noted, when going to stay at Jenny's, that I was sitting on trains next people with mobile phones, and yet my electrical sensitivity was down. I managed to ring S____ on the mobile, and hold it and not get ear pain.
7 May 2013
Today I take out the ‘apologies for short emails’ in my email signature. My hands are definitely better [less painful and fatigued] since using the earthing products.
July 2014
As at July 2014, I continue to use the grounding sheet on my bed at night. I consistently sleep through the night.
I continue to use a grounding mat beneath my keyboard and the level of pain in my hands is down.
If you are having trouble sleeping or experiencing a lot of physical pain, it's well worth the investment of around £30 or the equivalent. A grounding mat may be your answer to how to sleep or how to heal pain.
If funds are less of an issue, just go for it and try the grounding sheet.
And please do feel free to let me or all of us know on the healing forum if these healing products help you.
Healing affiliate disclosure
As you can tell from this page, I have personal experience
of the benefits of these earth energy healing products. I am proud to be an
affiliate, and if you click through and buy on my link, I will receive a
commission.
(Thank you if you do so.)
Please, as always, make your own decision about whether to
purchase these products. I know what it is to hope that something will work for you and I am only recommending this because it has made a real difference to me.
Move from Earth Energy Healing Products to read the Home Page about this Alternative Healing website.
Receive daily inspiration...
by putting your favorite (favourite) healing quote on
a mug, cushion, postcard, coaster, T shirt etc.
You will find my zazzle gift store at
zazzle.com/HealingStore.
Use one of my designs or start from a blank.
Thank you from me, Katherine, author of HealingCFSME.com
 |
© Katherine T Owen. All articles on this website are copyrighted. I am delighted if you choose to click above to share this page on social media, but please
do not copy, print or otherwise use without my permission. Thank you. Disclaimer:
I am not a medical practitioner. The articles on this website are not
to be taken as medical advice. Please consult a medical practitioner as
necessary. |